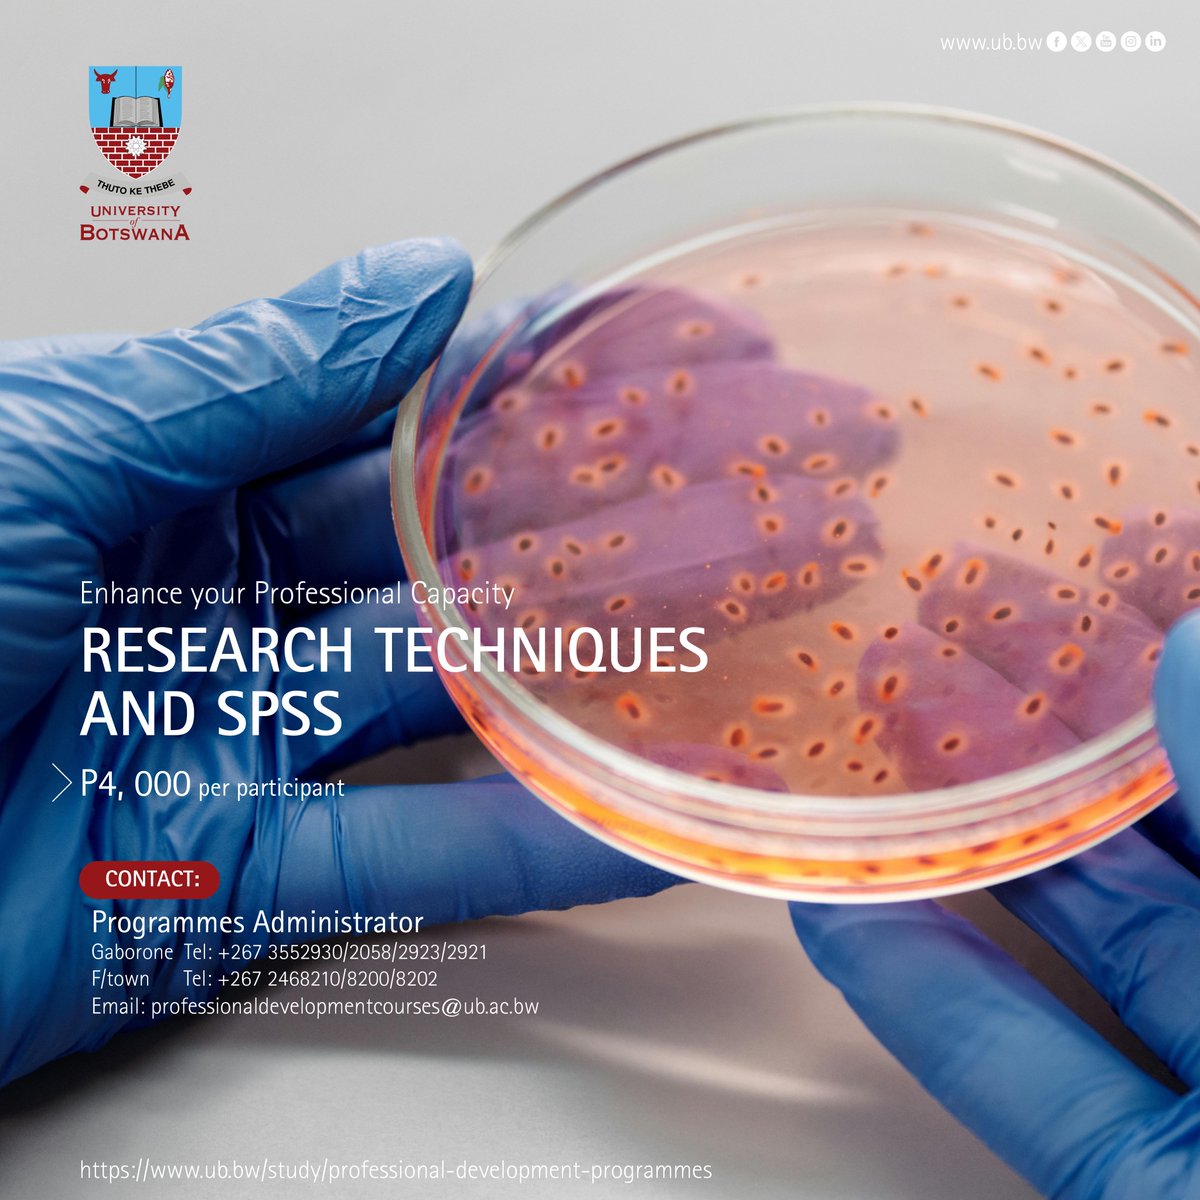
UBBotswana's tweet image. #ProfessionalDevelopmentCourse  RESEARCH TECHNIQUES AND SPSS 23rd – 25th September 2025 | Venue: University of Botswana, Gaborone.  
#EnrolNow: ub.bw/study/professi…

#professionaldevelopmentcourse search results
#ProfessionalDevelopmentCourse RESEARCH TECHNIQUES AND SPSS 23rd – 25th September 2025 | Venue: University of Botswana, Gaborone. #EnrolNow: ub.bw/study/professi…

#ProfessionalDevelopmentCourse CUSTOMER CARE SERVICE Date: 26th – 28th August 2025 | Venue: University of Botswana, Gaborone. #EnrolNow: ub.bw/study/professi…

“It was really beneficial to hear different views and perspectives on how to become a better professional. I have been able to implement the learnings at my workplace… to receive a great feedback from my manager on my improvement.” That’s a wrap! #ProfessionalDevelopmentCourse

#ProfessionalDevelopmentCourse PUBLIC SPEAKING DateL 11th – 14th August 2025 | Venue: University of Botswana, Gaborone. #EnrolNow: ub.bw/study/professi…

#ProfessionalDevelopmentCourse CHANGE MANAGEMENT Date: 28th – 30th October 2025 | Venue: Venue: University of Botswana, Gaborone. #EnrolNow: ub.bw/study/professi…

#ProfessionalDevelopmentCourse ENTREPRENEURSHIP Date: 22nd – 26th September 2025 | Venue: Venue: University of Botswana, Gaborone. #EnrolNow: ub.bw/study/professi…

Last month, we participated in some events in the USA 🇺🇸 and a webinar organized by @extendajunta and @consejeriauk for Spanish teachers in the UK 🇬🇧, and we raffled off a #ProfessionalDevelopmentCourse for #SpanishTeachers in #Seville, an authentic Spanish experience.


#ProfessionalDevelopmentCourse EFFECTIVE MINUTE TAKING Date: 11th – 13th November 2025 | Venue: University of Botswana, Gaborone. #EnrolNow: ub.bw/study/professi…

#ProfessionalDevelopmentCourse ENTREPRENEURSHIP Date: 3rd – 7th November 2025| Venue: Venue: University of Botswana, Gaborone. #EnrolNow: ub.bw/study/professi…

#ProfessionalDevelopmentCourse PROJECT MANAGEMENT Date: 26th – 28th August 2025 | Venue: University of Botswana, Gaborone. Enrol Now: ub.bw/study/professi…

#ProfessionalDevelopmentCourse CORPORATE GOVERNANCE Date: 28th – 31st October 2025 | Venue: University of Botswana, Gaborone. #EnrolNow: ub.bw/study/professi…

#ProfessionalDevelopmentCourse DIAL-A-SMILE Date: 26th – 27th November 2025| Venue: University of Botswana, Gaborone. #EnrolNow: ub.bw/study/professi…

#ProfessionalDevelopmentCourse OCCUPATIONAL HEALTH AND SAFETY Date: 23rd – 25th September 2025 | Venue: University of Botswana, Gaborone. #EnrolNow: ub.bw/study/professi…

#ProfessionalDevelopmentCourse EMOTIONAL INTELLIGENCE Date: 28th – 30th October 2025 | Venue: University of Botswana, Gaborone. #EnrolNow: ub.bw/study/professi…

There are so many exciting roles within the #LogisticsAndSupplyChainManagement industry! Prepare for them with an upcoming #ProfessionalDevelopmentCourse from #SHEL! #RegisterNow: 327-2499 | 723-1545 | [email protected] #SchoolOfHigherEducationLtd #Management

Ever wondered what is #SupervisoryManagement and why this is such an important role? Learn more at #SHEL's #ProfessionalDevelopmentCourse in Supervisory Management! Register Now: 327-2499 | 723-1545 | [email protected] #SchoolOfHigherEducationLtd #onlinecourses #Leadership

Spring semester of our #ProfessionalDevelopmentCourse is still open to all! Educators, counselors, and other professionals from across the US are encouraged to join: careerviewxr.bemorecolorful.com/cvxr-news/imme… An optional credit can be earned for $50 too! #ImmersiveLearning #Education #VR #EdChat

Are you ready to take your teaching career to the next level? Learn how to select the ideal professional development course for your needs and goals. #ProfessionalDevelopmentCourse #TeachingCareer #ChooseTheRightOne #BoostYourCareer stridepdcenter.com/blog/how-to-ch…
#ProfessionalDevelopmentCourse DIAL-A-SMILE Date: 26th – 27th November 2025| Venue: University of Botswana, Gaborone. #EnrolNow: ub.bw/study/professi…

#ProfessionalDevelopmentCourse EFFECTIVE MINUTE TAKING Date: 11th – 13th November 2025 | Venue: University of Botswana, Gaborone. #EnrolNow: ub.bw/study/professi…

#ProfessionalDevelopmentCourse ENTREPRENEURSHIP Date: 3rd – 7th November 2025| Venue: Venue: University of Botswana, Gaborone. #EnrolNow: ub.bw/study/professi…

#ProfessionalDevelopmentCourse CHANGE MANAGEMENT Date: 28th – 30th October 2025 | Venue: Venue: University of Botswana, Gaborone. #EnrolNow: ub.bw/study/professi…

#ProfessionalDevelopmentCourse EMOTIONAL INTELLIGENCE Date: 28th – 30th October 2025 | Venue: University of Botswana, Gaborone. #EnrolNow: ub.bw/study/professi…

#ProfessionalDevelopmentCourse CORPORATE GOVERNANCE Date: 28th – 31st October 2025 | Venue: University of Botswana, Gaborone. #EnrolNow: ub.bw/study/professi…

#ProfessionalDevelopmentCourse CUSTOMER CARE SERVICE Date: 21st -23rd October 2025 | Venue: University of Botswana, Gaborone. #EnrolNow: ub.bw/study/professi…

#ProfessionalDevelopmentCourse RESEARCH TECHNIQUES AND SPSS 23rd – 25th September 2025 | Venue: University of Botswana, Gaborone. #EnrolNow: ub.bw/study/professi…

#ProfessionalDevelopmentCourse OCCUPATIONAL HEALTH AND SAFETY Date: 23rd – 25th September 2025 | Venue: University of Botswana, Gaborone. #EnrolNow: ub.bw/study/professi…

#ProfessionalDevelopmentCourse ENTREPRENEURSHIP Date: 22nd – 26th September 2025 | Venue: Venue: University of Botswana, Gaborone. #EnrolNow: ub.bw/study/professi…

#ProfessionalDevelopmentCourse ENTREPRENEURSHIP Date: 22nd – 26th September 2025 | Venue: Venue: University of Botswana, Gaborone. #EnrolNow: ub.bw/study/professi…

#ProfessionalDevelopmentCourse ENTREPRENEURSHIP Date: 22nd – 26th September 2025 | Venue: Venue: University of Botswana, Gaborone. #EnrolNow: ub.bw/study/professi…

#ProfessionalDevelopmentCourse ENTREPRENEURSHIP Date: 22nd – 26th September 2025 | Venue: Venue: University of Botswana, Gaborone. #EnrolNow: ub.bw/study/professi…

#ProfessionalDevelopmentCourse PROJECT MANAGEMENT Date: 26th – 28th August 2025 | Venue: University of Botswana, Gaborone. Enrol Now: ub.bw/study/professi…

#ProfessionalDevelopmentCourse CUSTOMER CARE SERVICE Date: 26th – 28th August 2025 | Venue: University of Botswana, Gaborone. #EnrolNow: ub.bw/study/professi…

#ProfessionalDevelopmentCourse PUBLIC SPEAKING DateL 11th – 14th August 2025 | Venue: University of Botswana, Gaborone. #EnrolNow: ub.bw/study/professi…

#ProfessionalDevelopmentCourse PROJECT MANAGEMENT Date: 26th – 28th August 2025 | Venue: University of Botswana, Gaborone. Enrol Now: ub.bw/study/professi…

#ProfessionalDevelopmentCourse ENTREPRENEURSHIP Date: 22nd – 26th September 2025 | Venue: Venue: University of Botswana, Gaborone. #EnrolNow: ub.bw/study/professi…

#ProfessionalDevelopmentCourse CUSTOMER CARE SERVICE Date: 26th – 28th August 2025 | Venue: University of Botswana, Gaborone. #EnrolNow: ub.bw/study/professi…

#ProfessionalDevelopmentCourse PUBLIC SPEAKING DateL 11th – 14th August 2025 | Venue: University of Botswana, Gaborone. #EnrolNow: ub.bw/study/professi…

#ProfessionalDevelopmentCourse RESEARCH TECHNIQUES AND SPSS 23rd – 25th September 2025 | Venue: University of Botswana, Gaborone. #EnrolNow: ub.bw/study/professi…
#ProfessionalDevelopmentCourse CUSTOMER CARE SERVICE Date: 26th – 28th August 2025 | Venue: University of Botswana, Gaborone. #EnrolNow: ub.bw/study/professi…

#ProfessionalDevelopmentCourse PUBLIC SPEAKING DateL 11th – 14th August 2025 | Venue: University of Botswana, Gaborone. #EnrolNow: ub.bw/study/professi…

#ProfessionalDevelopmentCourse ENTREPRENEURSHIP Date: 22nd – 26th September 2025 | Venue: Venue: University of Botswana, Gaborone. #EnrolNow: ub.bw/study/professi…

Last month, we participated in some events in the USA 🇺🇸 and a webinar organized by @extendajunta and @consejeriauk for Spanish teachers in the UK 🇬🇧, and we raffled off a #ProfessionalDevelopmentCourse for #SpanishTeachers in #Seville, an authentic Spanish experience.


#ProfessionalDevelopmentCourse OCCUPATIONAL HEALTH AND SAFETY Date: 23rd – 25th September 2025 | Venue: University of Botswana, Gaborone. #EnrolNow: ub.bw/study/professi…

#ProfessionalDevelopmentCourse PROJECT MANAGEMENT Date: 26th – 28th August 2025 | Venue: University of Botswana, Gaborone. Enrol Now: ub.bw/study/professi…

“It was really beneficial to hear different views and perspectives on how to become a better professional. I have been able to implement the learnings at my workplace… to receive a great feedback from my manager on my improvement.” That’s a wrap! #ProfessionalDevelopmentCourse

#ProfessionalDevelopmentCourse CHANGE MANAGEMENT Date: 28th – 30th October 2025 | Venue: Venue: University of Botswana, Gaborone. #EnrolNow: ub.bw/study/professi…

Spring semester of our #ProfessionalDevelopmentCourse is still open to all! Educators, counselors, and other professionals from across the US are encouraged to join: careerviewxr.bemorecolorful.com/cvxr-news/imme… An optional credit can be earned for $50 too! #ImmersiveLearning #Education #VR #EdChat

#ProfessionalDevelopmentCourse EFFECTIVE MINUTE TAKING Date: 11th – 13th November 2025 | Venue: University of Botswana, Gaborone. #EnrolNow: ub.bw/study/professi…

There are so many exciting roles within the #LogisticsAndSupplyChainManagement industry! Prepare for them with an upcoming #ProfessionalDevelopmentCourse from #SHEL! #RegisterNow: 327-2499 | 723-1545 | [email protected] #SchoolOfHigherEducationLtd #Management

Ever wondered what is #SupervisoryManagement and why this is such an important role? Learn more at #SHEL's #ProfessionalDevelopmentCourse in Supervisory Management! Register Now: 327-2499 | 723-1545 | [email protected] #SchoolOfHigherEducationLtd #onlinecourses #Leadership

#ProfessionalDevelopmentCourse EMOTIONAL INTELLIGENCE Date: 28th – 30th October 2025 | Venue: University of Botswana, Gaborone. #EnrolNow: ub.bw/study/professi…

#ProfessionalDevelopmentCourse CORPORATE GOVERNANCE Date: 28th – 31st October 2025 | Venue: University of Botswana, Gaborone. #EnrolNow: ub.bw/study/professi…

#ProfessionalDevelopmentCourse DIAL-A-SMILE Date: 26th – 27th November 2025| Venue: University of Botswana, Gaborone. #EnrolNow: ub.bw/study/professi…

#ProfessionalDevelopmentCourse ENTREPRENEURSHIP Date: 3rd – 7th November 2025| Venue: Venue: University of Botswana, Gaborone. #EnrolNow: ub.bw/study/professi…

Something went wrong.
Something went wrong.
United States Trends
- 1. #DWTS 73.8K posts
- 2. Robert 115K posts
- 3. Elaine 42.2K posts
- 4. Alix 13.3K posts
- 5. Jordan 115K posts
- 6. Dylan 34.3K posts
- 7. NORMANI 3,950 posts
- 8. Carrie Ann 3,967 posts
- 9. Anthony Black 2,918 posts
- 10. #DancingWithTheStars 1,918 posts
- 11. Drummond 2,862 posts
- 12. Suggs 2,653 posts
- 13. #WWENXT 8,178 posts
- 14. Sixers 4,550 posts
- 15. Collar 30K posts
- 16. Godzilla 33.2K posts
- 17. Michigan 84.9K posts
- 18. Jalen Johnson 3,775 posts
- 19. Auburn 9,462 posts
- 20. #iubb 1,320 posts






